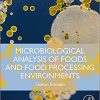
Microbiological Analysis of Foods and Food Processing Environments 1st Edition

Sorrentino’s Canadian Textbook for the Support Worker 5th Edition
by Mary J. Wilk RN GNC(C) BA BScN MN (Author)
Binder-Ready Edition: This loose-leaf copy of the full text is a convenient, accessible, and customizable alternative to the bound book. With this binder-ready edition, students can personalize the text to match their unique needs!
Learn to provide personal care and professional support in a variety of health care settings!Sorrentino’s Canadian Textbook for the Support Worker, 5th Edition helps you build the skills you need to succeed as a PSW (personal support worker). Illustrated, step-by-step guidelines to 93 procedures show how to perform your role safely and effectively. New to this edition are more case studies plus coverage of the latest issues relating to supportive care in long-term care facilities, hospitals, and home care. Written by Sheila Sorrentino, Leighann Remmert, and Canadian educator Mary Wilk, this text is known for its easy-to-understand approach, superb photographs, and comprehensive coverage. It’s no wonder thatSorrentino’s is the #1 book used by students in support worker programs across Canada.
Product Details
Product Details
- Publisher : Elsevier Canada; 5th edition (May 3 2021)
- Language : English
- Digital eBook : 1216 pages